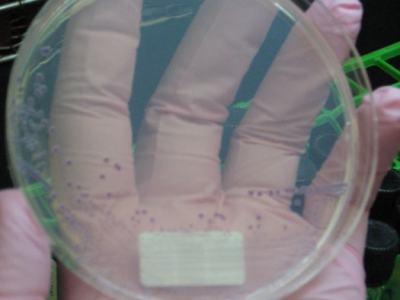
Silence on E. Coli outbreak highlights how Trump team’s changes undermine food safety

By Taylor Knopf
A new report by Disability Rights North Carolina found that a legal tool used to hold patients against their will for psychiatric treatment is frequently misused — violating patients’ rights and causing them long-term harm.
When a person is having a mental health crisis — such as if they’re thinking about suicide, acting erratically or experiencing hallucinations — they often end up in a hospital emergency department. They’re commonly brought in by a concerned family member or by police who have responded to a 911 call.
If a medical provider determines that the patient is a danger to themselves or to those around them, they will file a petition with the courts for an involuntary commitment custody order. These committed patients temporarily lose the right to make their own decisions while being treated for psychiatric problems or substance use. The process also usurps the rights of a parent or guardian to make health decisions for a child — a reality that surprises many family members and patients.
In this process, a patient doesn’t receive legal representation until they are admitted to an inpatient psychiatric facility. But that process can stretch out for days, weeks or, in some cases, months while waiting for an inpatient bed to become available, all at a cost of thousands — or tens of thousands of dollars — to individuals, private insurers or government-funded programs like Medicaid.

In the meantime, patients are held — unable to leave — in often chaotic hospital emergency departments without mental health treatment and without an attorney.
Requests for involuntary commitments have been on the rise in North Carolina for over a decade, increasing by at least 96 percent, according to data collected and reported by NC Health News, rising from about 54,000 in 2011 to more than 106,000 in 2021.
“It is this giant sledgehammer of a tool that is used for all manner of crises inappropriately, and it should be reserved for those very few, very limited number of cases where someone doesn’t have another option, really is posing risk of serious harm to self or others,” said Corye Dunn, who leads policy efforts at Disability Rights NC. The group is North Carolina’s federally mandated protection and advocacy organization charged with looking after the legal rights of people with disabilities.
The Disability Rights team conducted a yearlong investigation into the use of involuntary commitments in North Carolina. They monitored 10 emergency departments across the state and interviewed those involved in the commitment process, including hospital staff, legal experts and mental health advocates, as well as patients and their family members.
The organization found that the involuntary commitment process is frequently overused and misused to address behavioral health crises, and the state is not keeping track of how often or where that is happening.
“Shifts in policy and culture have advanced convenience over due process to the point that one psychiatrist describes IVC [involuntary commitment] as ‘the easy button,’” Disability Rights staff wrote in a comprehensive report released Tuesday. “This description bears out as evidenced by the ease with which IVCs are initiated as well as the sheer volume of petitions represented in the data.”
Disability Rights chronicled what the report called an “expensive, wasteful and abusive” process that leaves countless children and adults stuck in emergency departments — legally unable to leave — with no access to their phones, jobs, education, family or friends as they wait for a psychiatric bed to open, all while receiving little mental health treatment beyond medication.
The report makes more than 30 recommendations to improve North Carolina’s involuntary commitment process, including policy changes, procedural changes, data collection and calls for specialized professional education.
Violation of rights
North Carolina involuntary commitment laws allow adults and children to remain locked in an emergency department anywhere from days to months without any due process. Many are physically tied down, locked in rooms or chemically restrained, meaning they’re placed on drugs to subdue them.
The Disability Rights team went into emergency departments across the state and saw this problem up close.
“At one small, rural hospital, two men under IVC custody orders languished in the open on medical gurneys beside a nurse’s station because there wasn’t a private room available to them. The men used their sheets to cover their heads, perhaps to shield them from the bright lights and busy activity around them, and perhaps to provide some measure of dignity,” the report reads.
At another emergency department, Disability Rights staff saw a mental health patient in a four-point restraint, meaning his hands and feet were strapped down to his bed.
“This is almost like science fiction to me,” one hospital staff member told Disability Rights. “I am watching what is happening to human beings and wondering, are we actually helping people?”
The dense, 45-page report gives the example of one young man who was committed where the “facts” section of his petition was left blank, meaning it gave no reason for why he should be detained and treated involuntarily. The magistrate signed it anyway. He was held in the emergency room, handcuffed and transported by law enforcement — which is common practice.
Once he was admitted to a psychiatric hospital, his appointed attorney noticed the petition was blank and submitted a motion to a judge and had the commitment dismissed. Disability Rights asserts that he was illegally detained for five days.
“Even really savvy health care consumers, parents and advocates find it difficult to push back against the tide once this process starts,” Dunn said. “They’re just stuck.”
Parents hamstrung
Parents often find themselves blindsided by the involuntary commitment process, where they lose decision-making power over what happens to their children. Many are left in the dark about where their child is going or what treatment they’re being provided.
The Disability Rights report, which frequently cites reporting by NC Health News, includes an interview with Dan and Megan, parents of a child who was committed and taken to a facility against her parents’ wishes where she was mistreated and allegedly sexually assaulted by another patient. NC Health News reported the family’s experience and dug into additional complaints against the psychiatric hospital.

“That’s one of the hardest things — the helplessness. It was very hard to learn we were not in control of what was going to happen to her,” Dan told Disability Rights.
North Carolina law encourages voluntary treatment over involuntary, but that is not what happens in reality, the report found.
The report recommends amending state law to require that involuntary commitment petitions of adults under guardianship and children include information about the legal guardian’s and/or parents’ involvement in the patient’s care and why voluntary treatment could not meet the respondent’s needs.
“If the checkbox is on the form, then more magistrates ask questions about it,” Dunn said. “I think of them as speed bumps. They’re not barriers, but they slow you down enough to ask the questions, like ‘Does he want to go voluntarily?’”
Not enough data
Once a patient is under an involuntary commitment custody order, they must wait until hospital staff can find an inpatient bed in one of North Carolina’s psychiatric facilities. A patient can be held under a custody order for seven days, and if a bed is not found by then, the petition can be renewed.
According to state law, this can go on indefinitely.
Disability Rights found that these successive commitment petitions create a loophole where the patient continues to be held against their will without legal representation, because that only are assigned attorneys once they have been admitted to an inpatient bed — not while they wait in an emergency department. People detained in jails are arraigned within 72 hours of arrival — more due process rights than people who have been involuntarily committed.
The report recommends amending state law to eliminate successive petitions and to appoint legal representation to the patient at the time a magistrate issues the custody order so respondents can have timely representation.
The report also reveals that data on successive seven-day petitions is not kept, so there is no way to know how often or where this is happening.
The report found that roughly 37 percent of the total number of involuntary commitment petitions from the past six years were people who went on to receive forced psychiatric hospitalizations. That means 63 percent of petitions didn’t meet criteria for commitment or could be successive petitions on some of the same individuals.
There is no way of knowing what’s truly happening with the majority of petitions for involuntary commitment in this state because the data is not collected.
“So it is impossible to analyze where adjustments to law or policy should be made to prevent its wrongful, wasteful, or inefficient use,” the report reads.
The report recommends additional reporting and interpretation of data, including the outcomes of each petition for involuntary commitment and the number of people discharged from the emergency department after a custody order because they didn’t meet the criteria — danger to self or others — for an involuntary commitment.
It suggests making all data readily available to the public on an electronic dashboard, similar to one in Florida. Even the current limited amount of data is not easy to find.
‘Dumping’ patients
Nearly all of the emergency department leaders included in the report described instances where businesses and organizations would use the involuntary commitment process inappropriately to drop off patients — particularly children in the foster care system or older adults with dementia living in nursing homes.
Hospital administrators complained to Disability Rights NC that county Department of Social Services agencies from all over the state had dropped off kids that have been removed from their homes when they are unable to find foster family or other placement for them.
“I can appreciate it is hard for the DSS agencies, but it is not a receptacle for kids,” an attorney who represents children under involuntary commitment told Disability Rights staff. “I would be interested to see what can be done about DSS using hospitals as dumping grounds.”
The report mentions a hospital administrator in eastern N.C. who threatened to sue different social service agencies three times for room and board, which resulted in the agencies picking up their kids within days. Children in the foster care system are often the ones who end up living in emergency departments the longest, the report found.
“From the hospital perspective, it feels like these people who have a responsibility to these folks with disabilities have dumped them here and not given us any tools to deal with it,” Dunn said.
Rusty Miles, emergency department director at Carteret Health Care in Morehead City, told Disability Rights that housing foster children in the emergency department is a challenge.
“These kids don’t get the services they need — they miss school, socialization and outside play,” Miles said. “We do the best we can, but it’s a real disservice to keep these kids here.”
The report recommends an expansion of community-based care options to prevent overuse for patients who really shouldn’t be committed and who do not meet the criteria for an involuntary commitment. It also recommends looking into shifting costs for “frivolous” or repeated commitments to those agencies inappropriately seeking a commitment to leave patients at the emergency department.
Lawmakers chip away at the issues
When asked about some of these issues last week, Sen. Jim Burgin (R- Harnett) told NC Health News that if patients are inappropriately left at the emergency room by a county DSS or a nursing facility, that the hospitals “ought to be able to charge back to their facility for that.” He’s introduced legislation in the past that’s addressed a similar accountability issue.
Burgin had not seen a preview of the report, but he’s been a leader in the state Senate on mental health issues. He has requested — and accompanied Disability Rights staff — to visit psychiatric facilities in the past. He said he’s been keeping tabs on a few patients to see how they fare over time.

There is a 7-year-old child in his district who stayed in a local emergency department for 119 days, he recounted. And it wasn’t this child’s first involuntary commitment. Burgin said the 7-year-old has autism, and his behaviors sometimes become more than his single mother can handle. She takes him to the emergency room looking for help.
“I think involuntary commitment into an emergency room is a failure for us,” Burgin said. “Unless they are injured, that is not the place we need involuntary commitments to go. They’re not set up to handle them properly. They don’t have anything to take them to the next level of care. So basically, they get them in and check them, and then sedate them, do a telepsychiatry, or have somebody look at them, and then it’s a holding pen.
“We’re basically warehousing them until we find another place to put them,” he said.
Burgin called the entire process inappropriate and unnecessarily expensive. He emphasized the need to get ahead of the problem and provide adequate services up front so people don’t end up in emergency rooms and psychiatric hospitals with mental health issues.
“I want to fix this end of it, too, but we’ve got to get to the front of it. It’s the old adage about saving the kids coming down the river, but let’s also go up and stop the kids from ever getting in the river,” Burgin said. “We’ve got to deal with the other end of how these kids ever got in the situation that they end up being involuntarily committed.”
State lawmakers have put significant funding toward alternatives to the emergency department for patients in mental distress. In the 2023 budget, they allocated $835 million for behavioral health needs, with $80 million to increase crisis services and $20 million to start a non-law-enforcement transportation pilot program for mental health patients under involuntary commitment.
‘Your mortgage might not get paid’
The involuntary commitment process comes with a lot of trauma for patients being held against their will, even when they agree to treatment.
They are often strip-searched for items they could use to hurt themselves. They languish in emergency departments with no access to fresh air, sunlight, family or even their phones. Some experience being restrained, locked up or drugged into submission. Once a bed is available, they are then handcuffed and placed into the back of a law enforcement vehicle to be transported to the next facility.
Many find they are more harmed than helped through this experience. And then, when they’re discharged, they have to deal with the consequences of having been locked away. Forced hospitalizations have caused some to lose their jobs or housing, and they end up with medical debt from care they didn’t want, Disability Rights found.
“Your mortgage might not get paid. Your job doesn’t get done. Your kids need care,” Dunn said. “We have to stop pretending that people experiencing emotional distress are a different group of people. They are not sitting to the side with no responsibilities and no relationships.”
Research shows that people who have been involuntarily committed tend to subsequently distrust the medical system, and they can be reluctant to seek care in the future — sometimes with tragic consequences.
Mounting costs
Inpatient psychiatric hospitalization is expensive; costs can be more than $2,000 per day, depending on the facility. Disability Rights reports that even in the smoothest possible scenario — where a person goes to the emergency department and is quickly transferred to a psychiatric hospital and is released after a few days — the cost will be at least $10,000. A 30-day commitment order could easily equate to a $60,000 bill, according to the report.
“Unfortunately, the law says the patient is responsible for the cost even if they didn’t want the treatment,” the report states.
Involuntary commitments stay on an individual’s record and can prevent them from pursuing certain types of careers, as was the case for a 34-year-old man in western North Carolina, an example included in the report. He served in the National Guard and had been working as an EMT and volunteer firefighter for a decade when he was recruited for a law enforcement position. But he failed the firearms background check and was told he couldn’t move forward in his training at the law enforcement academy. The reason: He was involuntarily committed during a rough period of his life while a teenager.
The report recommends additional training for magistrates, who sign off on the initial custody order, on the impact of involuntary commitments and the alternative mental health crisis options available in the community. Magistrates in North Carolina do not have to be lawyers, and their training only includes four hours on the involuntary commitment process. Their annual continued education also doesn’t include information on involuntary commitments.
“If you want to prevent basically a carceral mental health system, you’ve got to provide something that’s less restrictive in the array of services,” Dunn said. “That’s peer respites. Respite for caregivers. Peer living rooms and resource hubs, and all the ways that we know we can provide support to people without locking them up.
“If we’re not doing that, we aren’t really serious as a state about our commitment to the well being of our residents.”
Bright spots of progress
The report highlights two hospitals that have recognized the harm and unnecessary burden of excessive involuntary commitments and launched initiatives to reduce their use.
WakeMed Health in Raleigh reduced its involuntary commitments by 60 percent, with most patients receiving care on a voluntary basis, hospital leaders reported to Disability Rights. To further reduce unnecessary distress and law enforcement involvement, WakeMed covers the cost of transportation for both voluntary and involuntary commitments.
In Avery and Watauga counties, similar progress is unfolding. Involuntary commitment rates there have also dropped by 60 percent. Before this initiative, “IVCs were passed out liberally, and there was a lack of understanding of the long-term impact,” said Stephanie Greer, president of the Avery Healthcare Market over Cannon Memorial Hospital and Appalachian Behavioral Health Hospital. “Magistrates were begging for guidance.”
In 2010, leaders from across the two counties formed a small, focused team to address the issue. They held each other accountable, even when discussions got uncomfortable, Greer said. One breakthrough came when a district court judge suggested requiring mental health assessments before magistrates issued custody orders. That led to the creation of crisis units at local hospitals and mobile crisis teams to evaluate patients before commitment petitions moved forward.
The impact has been substantial. Magistrates now issue custody orders only 40 percent of the time. Law enforcement involvement has also plummeted — from an average of 2,800 hours per month in 2010 to just 120 by 2015, according to Greer.
“Their work shows that when communities come together to solve an issue, they can design systems that work for them,” the report reads.













.jpg)

.jpg)
.jpeg)



Check the county jails too…Gaston county medical contract allows contractor to get paid more if they claim inmates are a danger and put them on suicide watch. Nurses are allowed to out anyone on watch, jail personnel not allowed to intervene, and only doctor can take them off. Medical obligation Contract states inmate should be evaluated within 3 days. It doesn’t happen. They wait until unit fills up. All the while collecting extra money. Then the doctor comes in and surprise surprise, most of those inmates are deemed to not even need help. But now they have been traumatized and so have their families. I chased this for years. Nobody cares.
Our family has experienced the horrific consequences caused by this law. We, like other parents, were broadsided with specifics of the process mandated by the law. Our child had been under the care of a renowned psychiatrist for many years. This terrifying episode stripped away the progress that had been made.
The Emergency Room physician told us they would not contact our child’s psychiatrist. Additionally, our child would be held in the Emergency Room area until a State Mental Health facility was available. Our child would then be transferred to the facility by the Sherriff’s Department in handcuffs. We asked to see our child but were denied access.
The ER physician was condescending and rude. Telling us to be quiet and not ask other questions.
It was a terrifying experience for our child and for us. We could not believe this was happening.